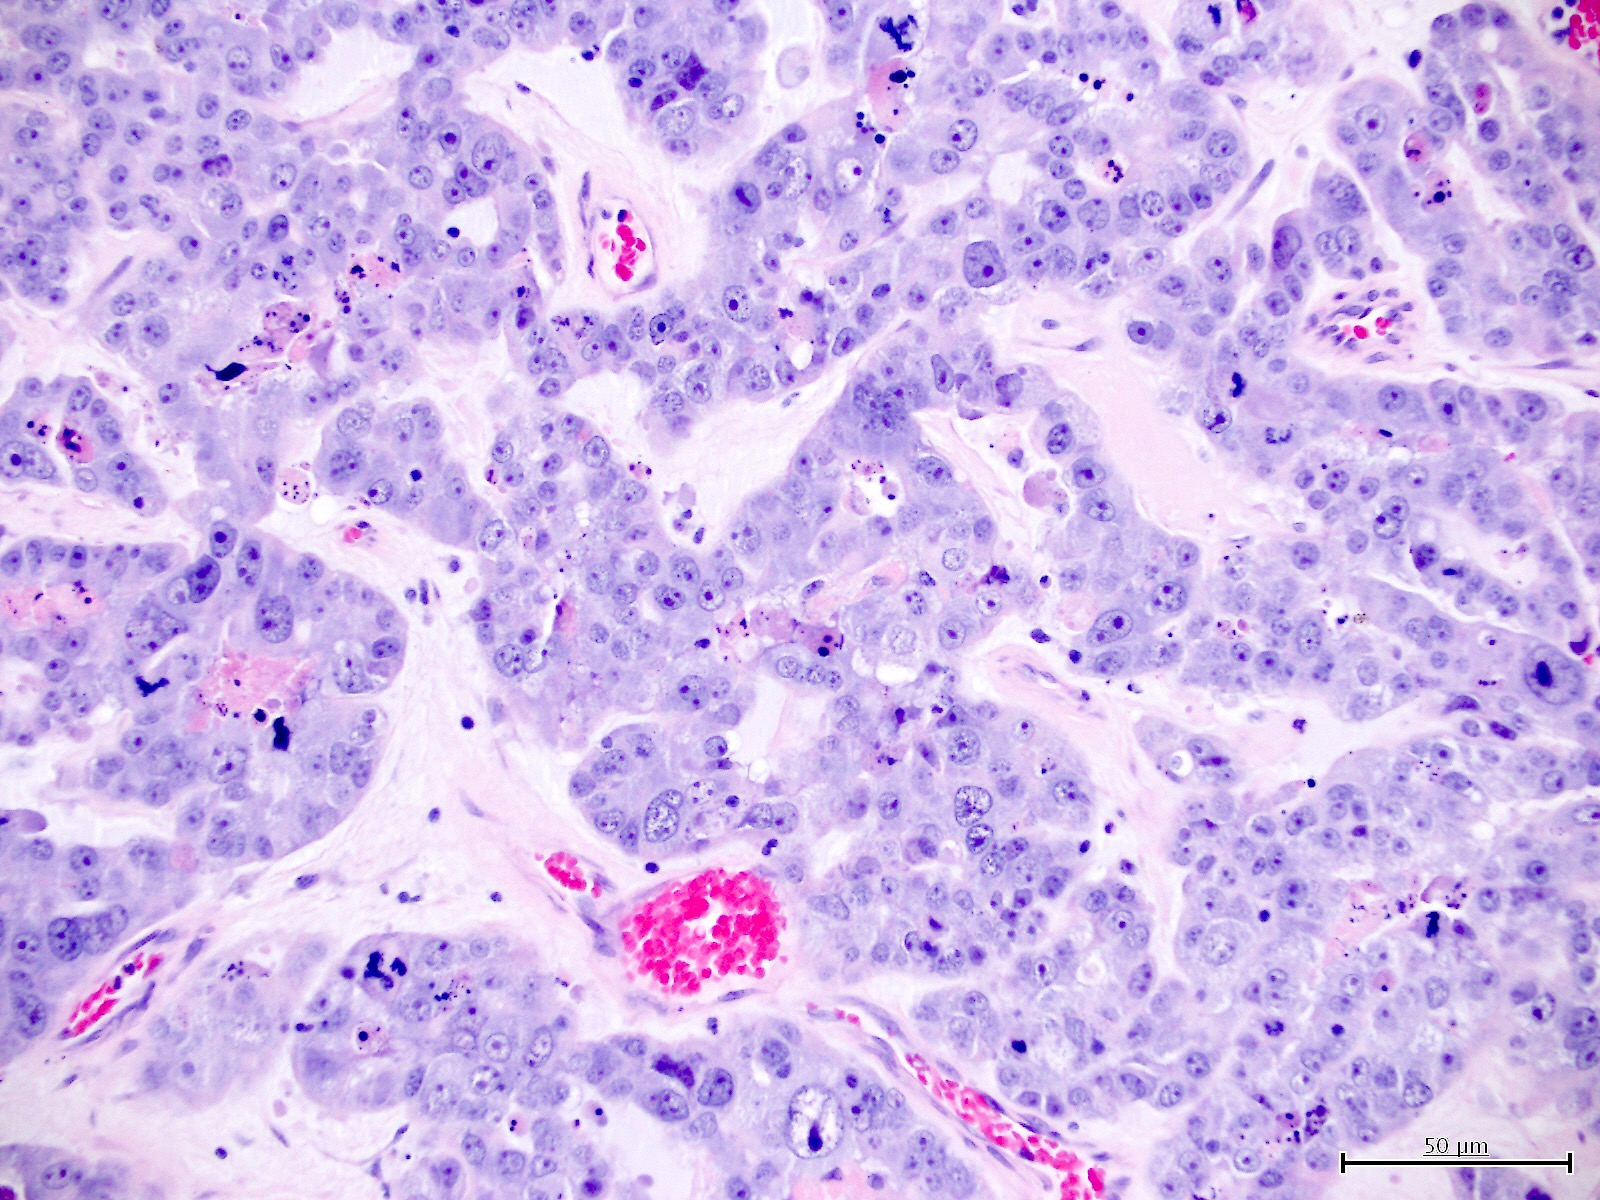

Table of Contents
Definition / general | Essential features | Terminology | ICD coding | Epidemiology | Sites | Pathophysiology | Etiology | Clinical features | Diagnosis | Prognostic factors | Case reports | Treatment | Clinical images | Gross images | Microscopic (histologic) description | Microscopic (histologic) images | Positive stains | Negative stains | Molecular / cytogenetics description | Sample pathology report | Differential diagnosis | Practice question #1 | Practice answer #1 | Practice question #2 | Practice answer #2Cite this page: Huvila J, Gilks CB. Clear cell carcinoma. PathologyOutlines.com website. https://www.pathologyoutlines.com/topic/uterusclearcell.html. Accessed September 15th, 2025.
Definition / general
- Tumor of postmenopausal patients that histologically resembles ovarian clear cell carcinoma with clear, oxyphil or hobnail cells
Essential features
- Diagnosed based on characteristic morphology
- Solid architecture more common than papillary
- HNF-1B, napsin A and AMACR positive
- Can be any of the 4 molecular subtypes of endometrial carcinoma but most common is no specific molecular profile (p53, mismatch repair and POLE wild type, estrogen receptor negative)
Terminology
- Also called clear cell adenocarcinoma
ICD coding
Epidemiology
- < 5% of all endometrial carcinomas (Am J Cancer Res 2013;3:70, J Pathol 2017;243:230, Int J Gynecol Cancer 2017;27:1714)
- Usually older, postmenopausal women (Int J Gynecol Cancer 2017;27:1714)
- Rarely associated with Lynch syndrome (Int J Gynecol Pathol 2019;38:S40)
Sites
- Uterus
Pathophysiology
- Heterogeneity of molecular pathogenesis (Histopathology 2015;66:664)
- All 4 molecular subtypes can be seen (p53 abnormal, mismatch repair deficient, POLE mutant and no specific molecular profile) (Histopathology 2015;66:664)
- p53 abnormal (serous-like) are aggressive, similar to other p53 abnormal endometrial carcinomas (Histopathology 2015;66:664)
- Mismatch repair deficient often shows mixed morphology, with clear cell and endometrioid components (J Natl Cancer Inst 2016;108:djv427)
- Only no specific molecular profile (p53, POLE and mismatch repair wild type) fit the classic clinical profile of clear cell carcinoma
Etiology
- Unknown
Clinical features
- Postmenopausal bleeding
- High grade carcinoma confined to the uterus in the majority of cases (Int J Gynecol Cancer 2017;27:1714)
- Associated with an increased risk for thromboembolic events (Int J Gynecol Cancer 2017;27:1714, Am J Cancer Res 2013;3:70)
Diagnosis
- Diagnosis is based on characteristic findings on an endometrial biopsy or curettage, which is typically performed for postmenopausal bleeding
- Abdominal and pelvic imaging can be performed for the purpose of clinical staging
Prognostic factors
- Age and stage are important prognostic factors (Am J Cancer Res 2013;3:70)
- p53 abnormal has worse prognosis (Int J Gynecol Pathol 2019;38:S40)
- Mismatch repair deficient and POLE mutant have more favorable prognosis (J Pathol 2017;243:230)
Case reports
- 66 year old woman with clear cell carcinoma present in endometrial polyps (J Menopausal Med 2016;22:122)
- 73 year old woman with tumor arising from adenomyosis (Int J Gynecol Pathol 2009;28:262)
Treatment
- Total hysterectomy and bilateral salpingo-oophorectomy
- Radiation therapy may be considered
Gross images
Microscopic (histologic) description
- Diagnosis should be based on the presence of prototypical morphologic (both architectural and cytological) features (Int J Gynecol Pathol 2019;38:S40)
- Cytological features (Am J Cancer Res 2013;3:70, Int J Gynecol Pathol 2019;38:S40)
- Polygonal cells with moderate to abundant clear or eosinophilic cytoplasm
- Hobnail cells and flat cells
- Occasional enlarged irregular nucleoli
- Variable cytological atypia
- Relatively low mitotic index
- High mitotic index or pleomorphic nuclei does not rule out clear cell carcinoma in an otherwise typical tumor
- Occasionally targetoid bodies, eosinophilic globules or psammoma bodies
- Architectural features (Am J Cancer Res 2013;3:70, Int J Gynecol Pathol 2019;38:S40)
- Solid, glandular or papillary architecture or a combination of these
- Stromal hyalinization (uncommon)
- No diffuse nuclear stratification in the papillary areas or diffuse columnar cell changes
Microscopic (histologic) images
Contributed by Jutta Huvila, M.D.
Positive stains
- HNF-1B (67 - 100%) (Histopathology 2015;66:664, Hum Pathol 2007;38:1074)
- Napsin A (56 - 93%) (Am J Surg Pathol 2014;38:189, Int J Gynecol Pathol 2018;37:388)
- AMACR (75 - 88%) (Hum Pathol 2013;44:2814, Hum Pathol 2019;92:10)
- Mismatch repair (MMR) expression (PMS2, MSH2, MSH6, MLH1) is intact in 80 - 90% (J Pathol 2017;243:230, Histopathology 2020;76:336)
- CK7
- p53 (wild type pattern in 67% of cases) (Int J Gynecol Pathol 2019;38:S40, Histopathology 2015;66:664)
Negative stains
- Estrogen receptor, progesterone receptor (most cases negative) (Histopathology 2015;66:664, Int J Gynecol Pathol 2018;37:388)
- CD10 usually negative (Arch Pathol Lab Med 2015;139:39)
Molecular / cytogenetics description
- ~50% are related to p53 abnormal, mismatch repair deficient or POLE mutant
- Remaining cases show occasional KRAS or PIK3CA mutations, without PTEN or TP53 abnormalities (Hum Pathol 2019;92:10)
Sample pathology report
- Endometrium, biopsy:
- Clear cell carcinoma of the endometrium (MMR intact, p53 wild type) (see comment)
- Comment: There is intact expression of mismatch repair proteins (PMS2 and MSH6) and wild type expression of p53, i.e. staining of variable intensity in < 80% of tumor cell nuclei.
Differential diagnosis
- Clear cell carcinoma of ovarian origin:
- Endometrial involvement is presumptive evidence of endometrial primary site
- Endometrial serous carcinoma (Am J Surg Pathol 2013;37:874):
- If p53 abnormal, then serous carcinoma unless completely typical clear cell carcinoma morphology
- Endometrioid endometrial carcinoma with clear cell or secretory change:
- Low grade nuclear features, associated atypical hyperplasia, estrogen receptor positive (strong, diffuse)
- Arias-Stella reaction:
- Younger age, associated pregnancy / progesterone treatment
- Normal glandular architecture
- Low Ki67 labeling index
- Clear cell carcinoma of cervical origin:
- Distinction is based on tumor site; no morphological distinguishing features
- Metastatic renal cell carcinoma, clear cell type:
- History of renal cell carcinoma
- Usually CK7, estrogen receptor and progesterone receptor negative (Arch Pathol Lab Med 2015;139:39)
- Usually positive for CD10 and HNF-1B (Arch Pathol Lab Med 2015;139:39)
Practice question #1

Which of the following is true about clear cell carcinoma of the endometrium (shown in the image)?
- It is associated with a favorable prognosis
- It is associated with high levels of estrogen exposure (endogenous or exogenous)
- There is molecular heterogeneity
- There is no association with Lynch syndrome
Practice answer #1
C. There is molecular heterogeneity. Clear cell carcinomas of the endometrium can be associated with mutations in POLE (in which case they have a very favorable prognosis), mismatch repair deficiency (which may be a result of Lynch syndrome), mutations in TP53 (poor prognosis) or none of the above.
Comment Here
Reference: Clear cell carcinoma
Comment Here
Reference: Clear cell carcinoma
Practice question #2
The immunoprofile of most endometrial clear cell carcinomas includes
- Immunonegativity for AMACR
- Immunopositivity for progesterone receptor
- Immunoreactivity for Napsin A
- Mutant pattern staining for p53
Practice answer #2
C. Immunoreactivity for napsin A. The immunophenotype of a majority of endometrial clear cell carcinomas is positivity for napsin A and AMACR, negativity for progesterone receptor and wild type staining pattern for p53.
Comment Here
Reference: Clear cell carcinoma
Comment Here
Reference: Clear cell carcinoma